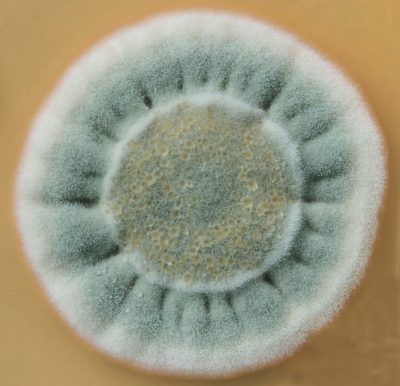
OLYMPUS DIGITAL CAMERA

Symmetry
Publicada el 8/03/2026
Título: Symmetry
Autor: Oliver Goldbeck
Schützenstraße 9 - 89231 Neu-Ulm - Germany
Descripción: A contamination found on a complex medium agar plate. The yet unidentified organism bears resemblance to Streptomyces species. Droplets of liquid can be seen in the center circle. The body of the organism recalls the radial symmetry of a flower.